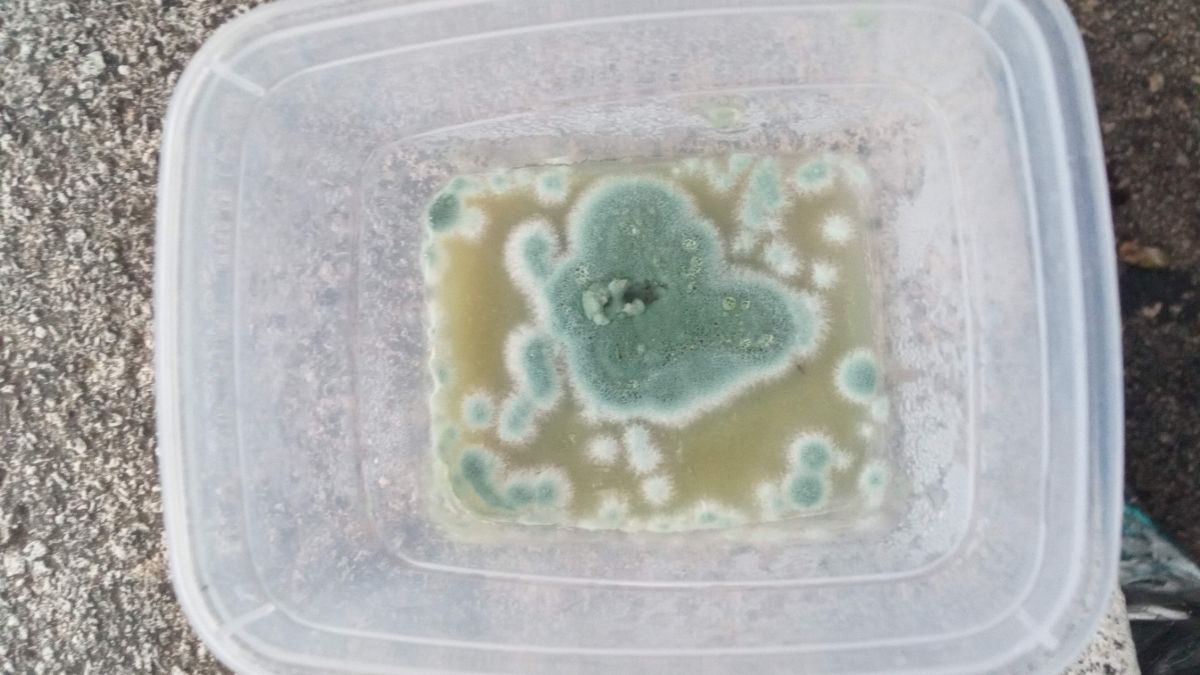
slika

Cekaj..treba im..Astralis je napisao/la:IMG_20190715_211906_resized_20190717_104142089.jpg
Second flush 4 dana nakon dunkanja i ponovnog postavljanja izgleda ovakoNema nikakvog mirisa
Nista se kao ne dogadja... Baciti ili cekati?
Kontaminacije
- AFX
- Moderator

- Postovi: 1287
- Pridružen/a: 13.01.2013, 21:34
- Has thanked: 596 times
- Been thanked: 492 times
Re: Kontaminacije
Svi moji postovi su izmišljeni tj. nemaju veze s stvarnošću i sve napisano je priča koja nema nikakve veze s stvarnim događajima i osobama.
"This is the biggest joke, I've ever played on ourselves"
"This is the biggest joke, I've ever played on ourselves"
Re: Kontaminacije
Pozdrav svima, dobri ljudi!
Ovako, ovo je moj first grow, u pitanju je Dutch King, metoda psenica, kokosov treset i vermikulit. Do sada je sve islo po planu, ali...
Pre mesec dana micelijum je premesten u kontejner, ali sve se jako sporo odvijalo, poceo je da se razvija fino i onda je sve stalo. Ceo kontejner bi trebao biti vec uveliko beo, ali to se ne desava, jednostavno nece da se siri, vidite na slikama. Zemlja je malo popucala na sredini. Na nekim mestima ima crne boje, al to kontam da su se spore prosule. Iz oba kontejnera sam vec ubrala po nekoliko pecuraka. Ali evo vec 2-3 dana nema nijedne ni na pomolu. Molim vas da mi pomognete, pogledajte ove slike, da li ima neke kontaminacije ovde? Sta mogu da uradim da im pomognem? Mozda mi temperatura nije dobra, evo danas sam uzela ventilator da to resim. Da li mozda treba malo vermikulita posuti po povrsini? Unapred zahvalna lady Joke!
Ovako, ovo je moj first grow, u pitanju je Dutch King, metoda psenica, kokosov treset i vermikulit. Do sada je sve islo po planu, ali...
- danko fafanko
- rank7

- Postovi: 286
- Pridružen/a: 03.05.2013, 15:41
- Has thanked: 29 times
- Been thanked: 58 times
Re: Kontaminacije
Mirise na vlagu i pecurkedanko fafanko je napisao/la:Pozdrav!
Dosta su loše slike,jel to gore kao neka paučina? Kakav je miris?
- danko fafanko
- rank7

- Postovi: 286
- Pridružen/a: 03.05.2013, 15:41
- Has thanked: 29 times
- Been thanked: 58 times
Re: Kontaminacije
Nisam, samo sam prskala sa strane pumpicom. Mislila sam da to namakanje treba samo za kejkove. Mozes li, pls, da mi ukratko pojasnis sta treba da uradim? Hvala tidanko fafanko je napisao/la:A jesi namakala u vodu to koji put?
- danko fafanko
- rank7

- Postovi: 286
- Pridružen/a: 03.05.2013, 15:41
- Has thanked: 29 times
- Been thanked: 58 times
Re: Kontaminacije
Trebalo bi to nekako potopiti u vodu na par sati al sad vidim da je popucalo pa ne znam jel je moguće.. Ne vidim kak su ti rupe na toj kutiji, jel bi se moglo u nju sipati voda a da ne iscuri?
Re: Kontaminacije
E pa, rupe su probusene oko cm iznad zemlje, mislim da je izvodljivo da potopim. Pokušaću to da uradim, nemam šta da izgubim. A zemlja je popucala na sredini. Samo mi reci, koliko dugo treba da drzim natopljeno i da li treba da prokuvam vodu ili da kupim vodu ili da sipam sa česme? Hvala ti puno što mi pomažeš.danko fafanko je napisao/la:Trebalo bi to nekako potopiti u vodu na par sati al sad vidim da je popucalo pa ne znam jel je moguće.. Ne vidim kak su ti rupe na toj kutiji, jel bi se moglo u nju sipati voda a da ne iscuri?
- danko fafanko
- rank7

- Postovi: 286
- Pridružen/a: 03.05.2013, 15:41
- Has thanked: 29 times
- Been thanked: 58 times
Re: Kontaminacije
Teško ćeš to izvest ako su rupe centimetar od zemlje al probaj nekako.. Prije toga poberi sve gljive i ostavi potopljeno bar 5,6 sati. Morat ćeš staviti gore nešta teško da drži supstrat jer će ti on kad sipaš vodu htjeti isplivati na površinu.. Voda može direkt iz česme